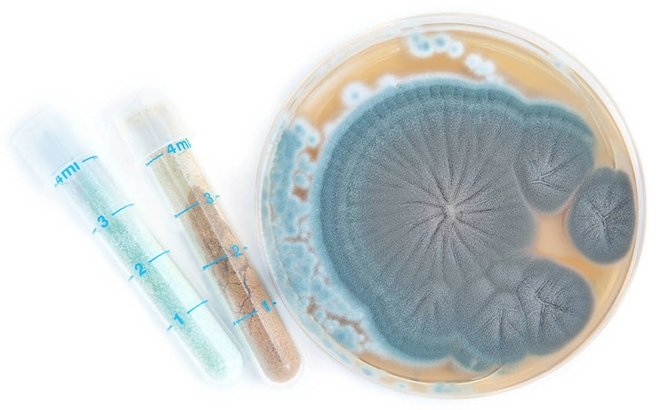
Penisilin

Tesadüf eseri bulunan 10 keşif
Bir kısmı günlük hayatımızda kullandığımız, sağlık sorunlarımızda şifa kaynağımız; bir kısmı ise ofis yaşamımızın baş kurtarıcısı veya sinema keyfimizin vazgeçilmezi… Onlar tesadüf eseri bulunan keşiflerden sadece bazıları…
Bir lokantada çalışan George Crum, 1853 yılında müşterilerine patates kızartmasını sunmaya hazırlanıyordu.
Müşterilerinden biri gelen patatesleri kalın buldu ve "daha ince daha kızarmış" olarak istediğini belirtti. Crum bunun üzerine sinirlenip, patatesleri inanılmaz derecede ince kesip, kupkuru olana dek kızarttı.
Şefi şaşırtan bir şekilde müşteri bu halini çok beğendi ve patates cipsi bu şekilde ortaya çıktı.
General Electric'te mühendis olarak çalışan James Wright, İkinci Dünya Savaşı'nda uçak lastikleri, asker botları ve başka şeyler için plastiğe ihtiyaç duyan ülkesi için silikon yerine plastik kullanmak istedi.
1943 yılında silikon yağının içine borik asit kattı ve şekil alabilen yumuşak hamur "oyun hamuru" olarak adlandırıldı.
Post-It olarak bilinen, ders çalışma ve ofis ortamlarının vazgeçilmez unsuru not kâğıtları, bir şirketin araştırmacıları Spencer Silver ve Art Fry tarafından keşfedildi.
Bu keşif, araştırmacıların kalıcılığı uzun olmasına rağmen maddeleri kesin olarak yapıştırmayan ve bir süre tutunmalarını sağlayan bir yapıştırıcı çalışmaları sırasında ortaya çıktı.